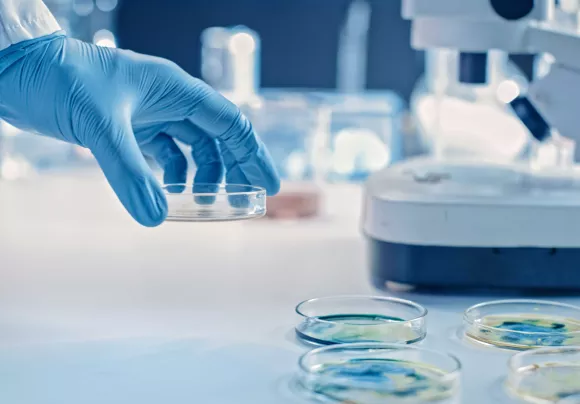
Verfahren

Mikrobiologische Verfahren
Mikrobiologische Keimanalyse mittels universaler und selektiver AgarNährmedien und selektiver Flüssig-Nährmedien mit quantitativer Keimzahlbestimmung
Die Abwasserwirtschaft trägt einen wesentlichen Teil zum Schutz der Gesundheit und Umwelt bei. Sauberes Wasser bildet die Grundlage für eine funktionierende Gesellschaft. Aufgrund des dringenden Handlungsbedarfs widmet sich das VTA Institut für Gesundheit und Umwelt der Erhaltung dieses wertvollen Gutes in allen technischen und wissenschaftlichen Fragestellungen.
Die Arbeit in unseren Laboren gliedert sich in Auftragsarbeiten sowie Forschungs- und Entwicklungstätigkeiten aber auch die Aus- und Weiterbildung liegt uns am Herzen.
Das VTA Institut für Gesundheit und Umwelt am Standort Rottenbach besteht aus 3 Laboren, die sich in die Hauptbereiche Chemie, Mikrobiologie und Molekularbiologie gliedern lassen.


Mikrobiologische Keimanalyse mittels universaler und selektiver AgarNährmedien und selektiver Flüssig-Nährmedien mit quantitativer Keimzahlbestimmung

Molekularbiologischer Nachweis von viraler RNA / DNA und Antibiotikaresistenzgenen bakteriellen Ursprungs in Wasserproben

Bestimmung der Aerosolmenge und Massenverteilung und Ermittlung der viralen und bakteriellen Aerosolbelastung

Qualitative / semi-quantitative Analysen von Wasserproben auf bestimmte Medikamentenklassen

komplette Abwasseranalytik, die die chemische Zusammensetzung des Abwassers charakterisieren
Analyse von Belebtschlamm mittels Licht- und Fluoreszenzmikroskopie, Färbe- und Fixationsmethoden
